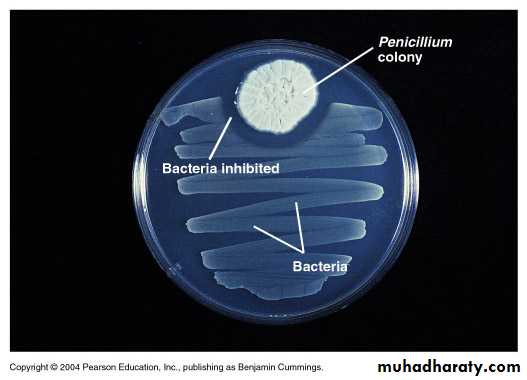

Introduction to Microbiology
1
Microbiology
What is Microbiology?Microbiology -The science of microorganisms (very small, unicellular organisms).Usually requires a magnification tool – the microscope.
Microorganisms or microbes- these microscopic organisms Commonly called “germs, viruses, agents…” but not all cause disease and many more are useful or essential for human life
Some organisms are large though – Helminths – worms
Sub groups of Microbes we will study
Bacteria
Archaea
Fungi
Protozoans
Algae
Viruses
Multicellular animal parasites – Helminths
2
3
4
Bacteria
5
Fungi
6
Protozoans
Giardia Ameba7
Viruses
Bacteriophage Avian Flu8
Helminth
Tapeworm9
Why Do We Study Microorganisms?
We study microbiology because bacteria, viruses and fungi are the leading cause of death in the history of mankind.Some Microorganisms Benefit Man:
- Many microorganisms are involved in the production of food or are directly edible.
- The presence of bacteria (normal flora) in our bodies inhibits the growth of potentially pathogenic bacteria helping to keep us healthy..
10
Why Do We Study Microorganisms?
Some Microorganisms Benefit Man:- Modern biotechnology is often associated with the use of genetically altered microorganisms such as E. coli or yeast for the production of substances like synthetic insulin or antibiotics.
- Biotechnological advances in agriculture also require the help of microorganisms to form Transgenic Plant with increased yield, reduced vulnerability to environmental and pathogenic stresses, and improved taste.
11
Why Do We Study Microorganisms?
Some Microorganisms Benefit Man:- Microbes are involved in cycling vital elements such as carbon and nitrogen, breaking down wastes and dead organisms into simpler substances plants can use in photosynthesis. Other species are at the base of the food chain, especially in aquatic ecosystems. Even pathogens have a role in controlling the populations of their host species. Microbes are even used to digest oil from oil spills.
12
13
14
15
16
Brief History of Microbiology
The MicroscopeFermentation and Pasteurization
Germ Theory
The Birth of Modern Chemotherapy
Antiseptics and Hand Washing
17
The First Microscope
Microbes were first observed by Antonie van Leeuwenhoek using a simple microscope (ca. 1676)
Reported his “animalcules” to the Royal Society of London
18
History
1676 –first observation of bacteria “animalcules”Anton Von Leeuwenhoek
19
Antoni van Leeuwenhoek
Inventor of the first microscope (1675)
20
The Golden Age of Microbiology
1857-1914Beginning with Pasteur’s work, discoveries included the relationship between microbes , Fermentation and Pasteurization
21
Pasteur showed that microbes are responsible for fermentation.
Fermentation is the conversation of sugar to alcohol to make beer and wine.Microbial growth is also responsible for spoilage of food.
Bacteria that use alcohol and produce acetic acid spoil wine by turning it to vinegar (acetic acid).
Fermentation and Pasteurization
22
Pasteur demonstrated that these spoilage bacteria could be killed by heat that was not hot enough to evaporate the alcohol in wine. This application of a high heat for a short time is called pasteurization.
Fermentation and Pasteurization
Figure 1.4
23
Louis Pasteur
Showed microbes caused fermentationStudied spoilage and introduced “Pasteurization” to prevent it
Used cotton plugs in his cultures to prevent air borne contamination, devised Aseptic Technique.
24
History
Louis Pasteur25
Louis Pasteur put an end to Abiogenesis debate with his
Goose Neck Flask Experiment
He is the father of Microbiology
26
Germ Theory of Disease
Proof that microorganisms caused diseaseRobert Koch demonstrated that anthrax was caused by Bacillus anthracis
Blood from a diseased animal caused disease in a healthy animal
Cultivated the disease causing agent outside the animal’s body, then introduced the agent into a healthy animal which subsequently developed the disease
27
Germ Theory of Disease
1876 - Robert Koch provided proof that a bacterium causes anthrax using experimental steps now called the Koch’s PostulatesHe was the first to use agar as solid culture medium in bacteriology.
28
29
30
31
32
Koch’s Postulates
The microbe must always be present in every case of the diseaseIt must be isolated in pure culture on artificial media
When inoculated into healthy animal host it should produce the same disease
It must be isolated from the diseased animal again
33
History
1884 Koch’s Postulates of Disease TransmissionRobert Koch
34
Treatment with chemicals is chemotherapy.
Chemotherapeutic agents used to treat infectious disease can be synthetic drugs or antibiotics.Antibiotics are chemicals produced by bacteria and fungi that inhibit or kill other microbes.
Quinine from tree bark was long used to treat malaria.
1910: Paul Ehrlich developed a synthetic arsenic drug, salvarsan, to treat syphilis.
1930s: Sulfonamides were synthesized.
The Birth of Modern Chemotherapy
35
1928: Alexander Fleming discovered the first antibiotic.
He observed that Penicillium fungus made an antibiotic, penicillin, that killed S. aureus.
1940s: Penicillin was tested clinically and mass produced.
The Birth of Modern Chemotherapy
Similar to Figure 1.5
36
History
1929 Discovery of Penicillin(first antibiotic)
Alexander Fleming
37
Antiseptics and Hand Washing
1860s -Joseph Lister used, carbolic acid, a chemical antiseptic to prevent surgical wound infections
Ignaz Semmelweis, a Hungarian physician introduced hand washing as a means of preventing transfer of puerpueral sepsis in obstetrical patients
38
Lister
Antisepsis in surgery39
History
1867 Antiseptic SurgeryJoseph Lister
40
Semmelweis
41
History
1938 – First Electron MicroscopeThe electron microscope is capable of magnifying biological specimens up to one million times. These computer enhanced images of 1. smallpox, 2. herpes simplex, and 3. mumps are magnified, respectively, 150,000, 150,000 and 90,000 times.
42
History
1885 - Vaccine against RabiesLouis Pasteur
43
History
1796 – First vaccine (smallpox)Edward Jenner
44
History
1954 Polio VaccineJonas Salk
45